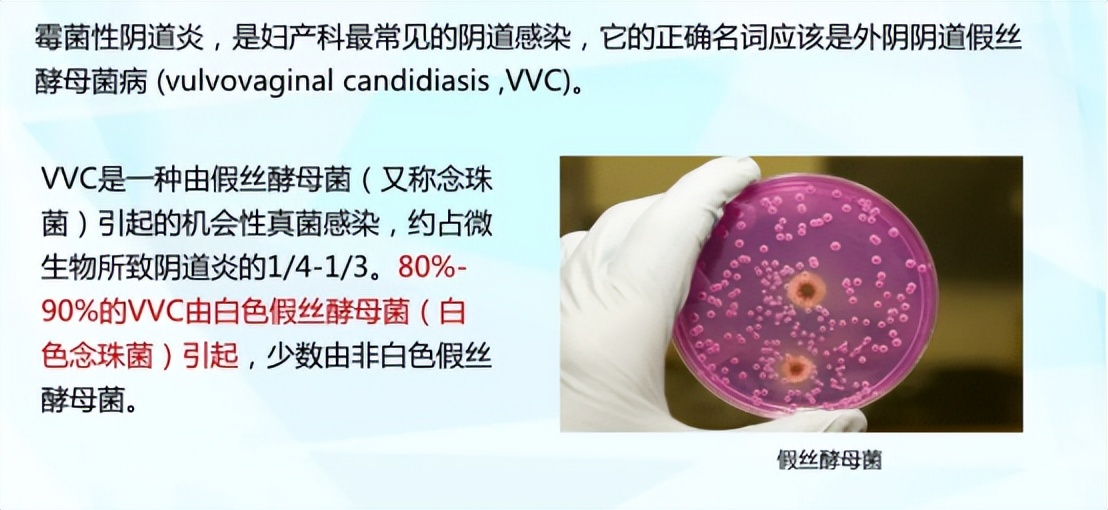
妇科检查这些坑不要踩,检查妇科病怎样避免踩雷

据有关数据统计,在女性群体中,约有75%的女性一生中至少患过一次霉菌性阴道炎(vulvovaginal candidiasis,VVC)。而50%的女性至少经历一次VVC的复发,45%的女性经历两次及以上的VVC发病。
在VVC患者中,约有80~90%为念珠菌类型为白色念珠菌感染。据最新的调查显示,复发性外阴阴道每年影响约1.38亿妇女(范围在1.03-1.72亿之间),3.72亿妇女在其一生中受到外阴阴道念珠菌病复发的影响,25-34岁人群患病率最高(9%)。这个霉菌性阴道炎到底是啥,我们怎样才能避免踩雷,如何幸运地成为剩下那25%健康人群呢?

近80%的霉菌性阴道炎都是由白色念珠菌引发的,其余20%的VVC也是由其同类非白念珠菌,如光滑念珠菌等诱发的。而这个白色念珠菌在大部分正常女性阴道中都有少量的定植,平时都不会诱发霉菌性阴道炎。只有当生殖道菌群失衡时,生殖道内的乳酸杆菌数量减少,它们才会趁机作乱,大量增殖,诱发VVC。
而在传统的VVC治疗中,多采用抗生素疗法,初次使用抗生素往往会在短期内有较好的效果。但是,这个VVC复发的频率很高,很多人都是反反复复遭受VVC的折磨,而且由于反复使用抗生素还筛选了耐药菌群,导致抗生素使用效果一次比一次差,不得不使用级别更高的抗生素,然而VVC却总是时不时地复发,成了众多女性朋友的梦魇。

我们都知道在妇科检查中有一项白带常规的阴道清洁度检测,分为Ⅰ~Ⅳ度,而区分标准为阴道优势菌群乳酸杆菌的多寡为判断标准。其中Ⅰ度阴道清洁度为女性健康的黄金标准,其评价标准为乳酸杆菌占生殖道菌群的90%以上。而在传统的抗生素疗法中忽略了有益菌的存在,停药后也没有补充有益菌,导致诱发VVC的霉菌在停药后大量增殖,VVC再次发作。
VVC反反复复?你需要——Jarro-Dophilus® Women's

Jarro-Dophilus® Women's由4种乳酸菌菌株组成:
• Lactobacillus crispatus卷曲乳杆菌LBV 88=DSM 22566
• Lactobacillus rhamnosus鼠李糖乳杆菌LBV 96=DSM 22560
• Lactobacillus jensenii詹氏乳杆菌LBV 116=DSM 22567
• Lactobacillus gasseri格氏乳杆菌LBV 150N=DSM 22583
该菌株组合已在临床研究中被证明可以支持维持健康的阴道微生物群,能辅助改善女性细菌阴道炎和霉菌性阴道炎。
Jarro-Dophilus® Women 结合了结合了女性体内天然存在的最普遍的阴道乳酸杆菌种类,临床证明其有效数量为 5 - 100 亿,有助于恢复健康的阴道菌群。专利菌株可产生乳酸和过氧化氢 (H2O2),临床研究表明可降低阴道 pH 值,营造温和酸性和更健康的微生物环境。
45年专业益生菌品牌——Jarrow formula®
作为作为拥有数百万消费者的国际知名膳食补充剂品牌,Jarrow formula由Jarrow先生于1977年在美国洛杉矶创立的,目前畅销欧、美、亚洲。

在Jarrow众多优质的产品中,其益生菌类产品最受推崇,曾在2019年和2021年2次被美国专业测评机构ConsumerLab评选为客户满意度第一益生菌品牌。其独有EnteroGuard的包衣技术,进一步加持菌株的稳定性,让其能更好的抵御胃酸的侵蚀。

目前Jarrow杰诺品牌在国内已经终止了和Princess Luna(月神或小月神)终止了合作,并在天猫国际陆续开始预售,请锁定天猫店铺——Jarrow海外旗舰。